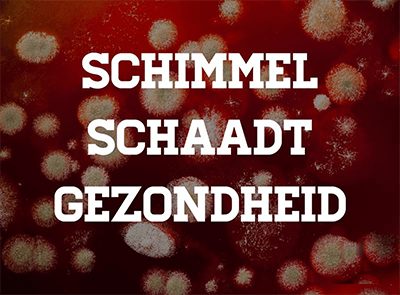
Schimmel

Schimmel binnenshuis slecht voor gezondheid!
Vocht, schimmels en ventileren
De lucht in een woning vervuilt snel door aanwezigheid en gedrag van bewoners. In een vochtig huis is meer huisstofmijt en groeien schimmels sneller dan in een droog huis. Het is belangrijk om de lucht in huis zo schoon, droog en gezond mogelijk te houden. Dit doet u door te ventileren en te luchten.
Wat doet de GGD
Het team Milieu en Gezondheid kan adviseren bij gezondheidsklachten en vocht en schimmel in huis. Het advies is gericht op dingen die u kunt doen om vocht en schimmel tegen te gaan en om te zorgen voor een gezonde binnenlucht.
De GGD doet géén keuringen van woningen en onderzoekt geen schimmels.
Wat u zelf kunt doen
Op de website ggdleefomgeving leest u meer over vocht, schimmels en ventileren. U vindt er informatie over wat u zelf kunt doen en de website geeft antwoorden op veel gestelde vragen over:
- Gezondheidsklachten door schimmels
- Schimmels weghalen
- Vocht in huis: dé oorzaak van schimmels
- Tips voor minder vocht in huis
- Uw huis goed verwarmen
- Voldoende ventileren
Bouw- en Woningtoezicht
Als er bouwtechnische gebreken zijn moet dit bij de verhuurder gemeld worden. Bijvoorbeeld bij lekkage of als het ventilatiesysteem niet goed werkt. Wil de verhuurder niet meewerken? Dan kunt u in veel gevallen advies vragen bij het juridisch loket en naar de huurcommissie stappen. In Amsterdam en Amstelveen ondersteunt stichting !WOON bij vragen over huren, onderhoud, huurrechten en -plichten en vele andere woonkwesties.
De afdeling Bouw- en Woningtoezicht van de gemeente kan handhaven bij bouwtechnische gebreken wanneer de verhuurder geen actie onderneemt. In Amsterdam heeft elk stadsdeel een afdeling Bouw- en Woningtoezicht, bouwinspectie@purmerend.nl . (Bel 0299 452 452).
Op de site van de gemeente staat een stappenplan voor hulp of advies in geval van problemen met de woning.
Zie: Vochtproblemen voorkomen en oplossen
Eisen voor ventilatie zijn vastgelegd in het Bouwbesluit, zowel voor oude als nieuwe woningen. Ook technische eisen aan woningen zijn vastgelegd in het bouwbesluit. Bouwtechnische gebreken zoals lekkages, kapotte ventilatieroosters of een verstopt ventilatiekanaal hoort de woningeigenaar op te lossen.
> Filmpjes over vocht en schimmel
> Woon! Vocht en schimmels
Als je ergens niet op zit te wachten in huis, dan is het wel op schimmel. Vocht en schimmel in huis zijn ergernissen nummer één. Helaas komen ze vaak voor, met name in badkamers en keukens. Het is een hardnekkig probleem. Vocht- en schimmelplekken zijn lelijk en ook nog eens ongezond. Gelukkig kun je er iets aan doen om hier niet langer mee te maken te hebben en weer in een gezonde leefomgeving te wonen.
De oorzaak van schimmel in huis
Schimmel wordt veroorzaakt door vocht. Een slechte ventilatie of lekkage in huis zorgen ervoor dat vocht zich ophoopt, waardoor lelijke, zwarte vlekken op muren en plafond verschijnen. De huizen van tegenwoordig zijn goed geïsoleerd. Bij een slechte ventilatie kan het vocht nergens heen en zal het zich gaan hechten aan plafonds en muren. Daarom is een vochtanalyse hiervoor een goede oplossing.
Kenmerken van vocht en schimmel
Je kunt vocht en schimmel in huis aan diverse kenmerken herkennen. Schimmel in huis herken je aan verkleuring, bepaalde textuur of geur. Vocht kun je herkennen aan de volgende kenmerken:
- Je ziet zwarte of groene vlekken;
- Er hangt een muffe geur in de ruimte;
- Er lopen zilvervisjes of pissebedden rond;
- Het behang laat los;
- Condensvorming op de ramen;
- Je hebt hogere stookkosten.
Tip 1: Frisse lucht
Zorg ervoor dat je woning voldoende wordt geventileerd. Laat regelmatig een bovenraam openstaan, ook in de winter. Vergeet niet te ventileren in de ruimte waar je was hangt te drogen. Ventileer ook de keuken en de badkamer. Droog de douchecabine na iedere douchebeurt met een trekker.
Tip 2: Gebruik een mondkapje bij verwijderen
Heb jij toch schimmel in huis? Verwijder die lelijke, zwarte plekken dan zo snel mogelijk. Ze kunnen zorgen voor ernstige gezondheidsklachten. Je kunt de plekken het beste zo snel mogelijk verwijderen. Hoe je je schimmel het beste kunt verwijderen? Gebruik tijdens het schoonmaken altijd een mondkapje en handschoenen. Tijdens het verwijderen kunnen schimmelsporen zich verspreiden. Om dit te voorkomen, kun je gebruikmaken van een sopje en vochtige doek.
Tip 3: Zorg voor de juiste schoonmaak
Er zijn meerdere manieren hoe je schimmel kunt verwijderen. Bleek met chloor werkt prima. Gebruik één deel bleek op twintig delen water. Spuit het mengsel vervolgens met een plantenspuit op de vlek en laat het tien minuten intrekken. Verwijder het goedje met een vochtige doek.
Azijn met zuiveringszout is een milieuvriendelijkere oplossing. Je hoeft de azijn en het zout niet te verdunnen, het kan rechtstreeks op de schimmelplekken aangebracht worden. Veeg met een vochtige doek het azijn en zout weer weg.
Tip 4: Voorkom schimmel met speciale badkamerverf
Voorkomen is natuurlijk nog altijd beter dan genezen. Vochtige ruimtes kun je schimmelvrij houden door op de muren en plafonds een speciale verflaag aan te brengen. Deze schimmelwerende verf breng je pas aan als je de muren en plafonds volledig schimmelvrij hebt gemaakt. De schimmel kan zich niet hechten aan deze verf.
Tip 5: Lekkage?
Heb je geprobeerd de schimmel weg te poetsen en blijft het hardnekkig terugkomen? Dan is er waarschijnlijk meer aan de hand. Het is raadzaam om in dat geval een inspecteur van Keuringsdienst voor Wonen langs te laten komen om de bron van het schimmelprobleem op te sporen. Het kan namelijk zijn dat je last hebt van een lekkage. Dit kan veroorzaakt zijn door een bouwfout of veroudering van de woning.
Een onderzoek laten uitvoeren door Keuringsdienst voor Wonen?</strong>
Keuringsdienst voor Wonen kan voor jou een lekdetectie en vochtonderzoek uitvoeren. Je huis wordt dan grondig geïnspecteerd en naar aanleiding van het resultaat, zal onze inspecteur advies geven waarmee jij het vochtprobleem kunt bestrijden. Neem gerust contact met ons op voor meer informatie.








